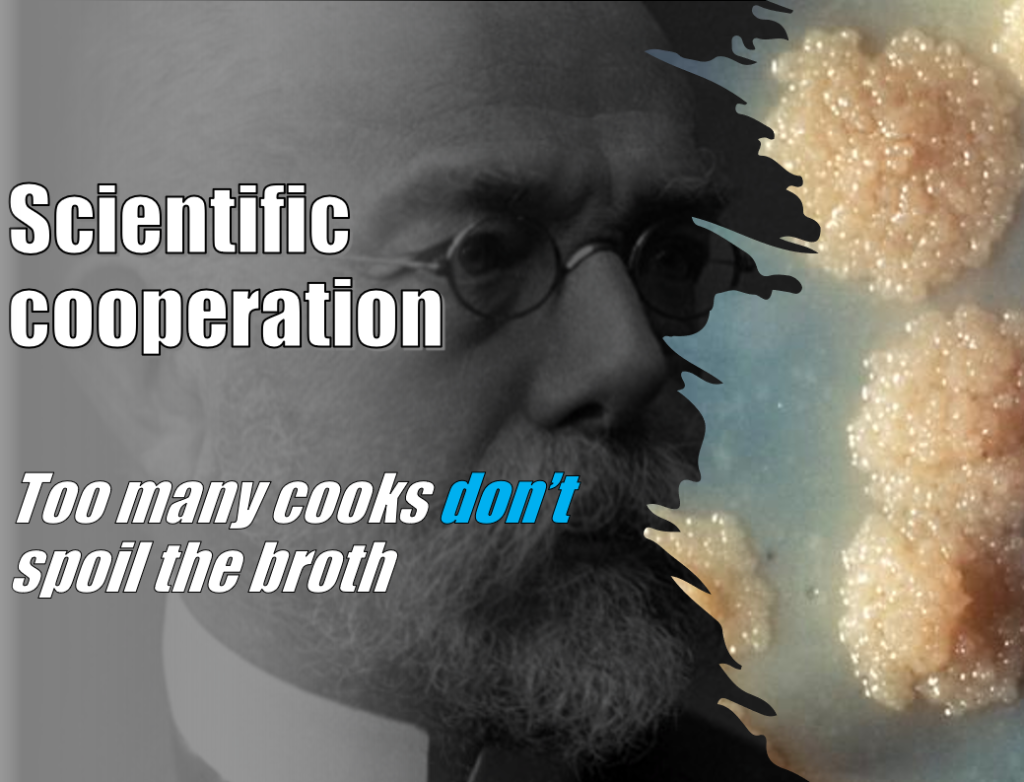

Updates from a very busy year Now that we can safely travel again, there’s some catching up due for PersonalizeAF members! Okay, let’s take this out of the way from the git-go: this blog has been a bit silent for quite a while. I have no excuse for that except to say that I and …

Research = exchange From the EP-lab to a basic research lab Hallo! Wie geht’s? It’s been a while since I last posted. So long, that I even changed from speaking in Catalan to German in the work environment. “How so? Weren’t you doing your PhD in Barcelona?”, you may ask. And you’re right, but as …
Scientific Cooperation: Too many cooks don’t spoil the broth close up shot of M. tuberculosis, arranged in colonies (CDC/Dr. George Kubica, Public Health Image Library 1976) This time we are starting way back, 9 thousand years to be precise; to an untimely death of a mother and her infant in the eastern mediterranean, – taken …

Science and Art: Beauty in the Lab A painting of sea roses by Claude Monet and a fluorescence image of a coculture, can you tell where one begins and the other ends? Bull’s head sculpture by Pablo Picasso, made from a bicycle’s seat and handlebar Because this post is going to be about art, it …

Success and Failure Failure is all around the academic career, be that during experiments or grant applications. But is this always a bad thing? How to deal with it? A while ago, Teresa made a post here talking about imposter syndrome and perseverance during the PhD. I had been wondering about similar topics myself. Reading …

How a young chess champion from the rural town of Famaillá, Tucumán, Argentina became a nuclear engineer working on Atrial Fibrillation in Norway Hi everyone, my name is Sergio Nabil Gadur. I am 27 years old. I come from the northern part of Argentina. My town is characterized by the National Festival of Empanada and …

One year on.. The more you know, the less you know! Hey everyone! This is Narimane Early-Stage researcher number 10 from Bordeaux. Now I am on my way to the land of cheese and chocolate, I thought it’s the perfect timing for writing. I am really thrilled to finally type down another blog post, after a …

CinC 2021, In-person meetings closer and closer I remembered Computing in Cardiology (CinC) as a lovely experience. CinC 2019 was my first glimpse into the academic world. I had just finished my bachelor’s degree and I was presenting part of my thesis in an international conference. It was my first conference, as well as the …

Matching online faces with funny people It has been a long time but always for a good reason 😉 It sounds crazy but today is exactly one year since I started my PhD in Karlsruhe. I have not always been happy during corona winter months, but we made it until here and finally it happened: …

Gutta cavat lapidem Hi everybody, it’s been a while, but here I am again. The past months have been quite intense, many collaborations in the pipeline and a lot of networking. Those of you who follow me on twitter might already know that I participated in a scientific retreat (CRC). It’s been a somehow unexpected …





